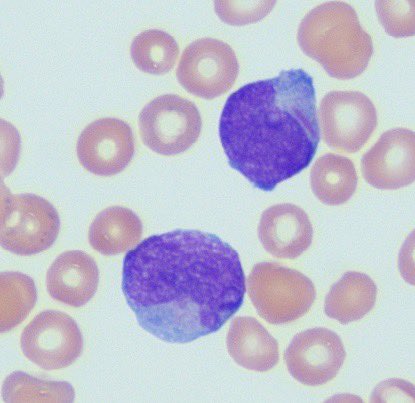
Nourhan Ibrahim (@nourhan_path22) on Twitter photo Auer rod is Auer RODING! Auer rod is Auer RODING!

Nourhan Ibrahim
@nourhan_path22
Egyptian 🇪🇬, PGY3 Pathology resident, #UTHSC_Houston, (tweets are my own).
ID: 1446868687206723585
09-10-2021 16:02:42
320 Tweet
1,1K Followers
598 Following





Had a great time at the #UTHoustonPath happy hour!😁 Texas Society of Pathologists #PathX



Truly honored to receive the Scholarly Activity Award. Beyond grateful! UTHealth Houston Pathology




81 y.o. M, cystectomy specimen. What is your diagnosis? #PathTwitter Mass General Brigham Pathology MGH Pathology






Mai Elzieny This is amazing. Thank you. I recently made a WSI search engine specifically thought for residents studying for Boards! It includes the sources you mentioned and a few more. :) pathologybites.com/tools/virtual-…





So glad I was able to present the UTHealth Houston Pathology Career Focus Track during the Association of Pathology Chairs meeting!😊🏫🔬 #GME #PathX #PathResidency